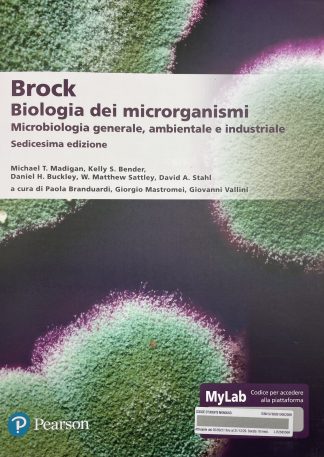

Pearson
Visualizzazione di 1-12 di 29 risultatiOrdina in base al più recente
-

Biochimica. Molecole e metabolismo. Ediz. mylab. Con eText. Con aggiornamento online
In offerta! Il prezzo originale era: 57,00 €.54,15 €Il prezzo attuale è: 54,15 €.di Dean R. Appling, Spencer J. Anthony-Cahill
-

Campbell. Meccanismi dell’evoluzione e origini della diversità. Ediz. mylab. Con espansione online
In offerta! Il prezzo originale era: 27,00 €.25,65 €Il prezzo attuale è: 25,65 €.di Campbell, Reece
-

Elementi di ecologia. Ediz. MyLab. Con Contenuto digitale per accesso on line
In offerta! Il prezzo originale era: 38,00 €.36,10 €Il prezzo attuale è: 36,10 €.di Thomas M. Smith, Robert L. Smith, e al.
-

Fisiologia umana. Un approccio integrato. Ediz. MyLab. Con Contenuto digitale per accesso on line
In offerta! Il prezzo originale era: 63,00 €.59,85 €Il prezzo attuale è: 59,85 €. -

Matematica per le scienze. Ediz. mylab. Con Contenuto digitale per download e accesso on line
In offerta! Il prezzo originale era: 34,00 €.32,30 €Il prezzo attuale è: 32,30 €.di Angelo Guerraggio
-

Stechiometria e laboratorio di chimica generale. Eserciziario. Ediz. MyLab
In offerta! Il prezzo originale era: 28,00 €.26,60 €Il prezzo attuale è: 26,60 €.di Maurizio Bruschi, Federica Arrigoni, e al. -
Brock. Biologia dei microrganismi. Microbiologia generale, ambientale e industriale. Ediz. Mylab. Con aggiornamento online
In offerta! Il prezzo originale era: 70,00 €.64,50 €Il prezzo attuale è: 64,50 €. -

Biologia molecolare. Principi di funzionamento del genoma. Ediz. illustrata
In offerta! Il prezzo originale era: 86,00 €.81,70 €Il prezzo attuale è: 81,70 €.di Nancy L. Craig,
-

Campbell. Biologia e genetica. Ediz. mylab.
In offerta! Il prezzo originale era: 42,00 €.39,90 €Il prezzo attuale è: 39,90 €.di Campbell, Reece
-

Fluency. Conoscere e usare l’informatica. Ediz. MyLab. Con espansione online
In offerta! Il prezzo originale era: 40,00 €.38,00 €Il prezzo attuale è: 38,00 €. -

Fondamenti di fisica. Ediz. MyLab. Con Contenuto digitale per accesso on line
In offerta! Il prezzo originale era: 63,00 €.59,85 €Il prezzo attuale è: 59,85 €. -

Biologia farmaceutica. Biologia vegetale, botanica farmaceutica, fitochimica. Ediz. Mylab. Con aggiornamento online
In offerta! Il prezzo originale era: 45,00 €.42,75 €Il prezzo attuale è: 42,75 €.
Visualizzazione di 1-12 di 29 risultatiOrdina in base al più recente
